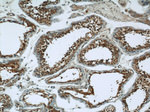
RAB3GAP1 Antibody in Immunohistochemistry (Paraffin) (IHC (P))

Search
Proteintech
RAB3GAP1 Polyclonal Antibody
{{$productOrderCtrl.translations['antibody.pdp.commerceCard.promotion.promotions']}}
{{$productOrderCtrl.translations['antibody.pdp.commerceCard.promotion.viewpromo']}}
{{$productOrderCtrl.translations['antibody.pdp.commerceCard.promotion.promocode']}}: {{promo.promoCode}} {{promo.promoTitle}} {{promo.promoDescription}}. {{$productOrderCtrl.translations['antibody.pdp.commerceCard.promotion.learnmore']}}
产品信息
21663-1-AP
种属反应
已发表种属
宿主/亚型
分类
类型
抗原
偶联物
形式
浓度
规格
纯化类型
保存液
内含物
保存条件
运输条件
产品详细信息
Immunogen sequence: PGDAGKAGD QLVPDNLKET DKEKGEVGKS WDSWSDSEEE FFECLSDTEE LKGNGQESGK KGGPKEMANL RPEGRLYQHG KLTLLHNGEP LYIPVTQEPA PMTEDLLEEQ SEVLAKLGTS AEGAHLRARM QSACLLSDME SFKAANPGCS LEDFVRWYSP RDYIEEEVID EKGNVVLKGE LSARMKIPSN MWVEAWETAK PIPARRQRRL FDDTREAEKV LHYLAIQKPA DLARHLLPCV IHAAVLKVKE EESLENISSV KKIIKQIISH SSKVLHFPNP EDKKLEEIIH QITNVEALIA RARSLKAKFG TEKCEQEEEK EDLERFVSCL LEQPEVLVTG AGRGHAGRII H (502-851 aa encoded by BC146809)
靶标信息
RAB3GAP1, is a 981 amino acid protein that belongs to the Rab3-GAP catalytic subunit family. Rab 3 GAP p130 converts active RAB3-GTP to the inactive form RAB3-GDP, and is required for normal eye and brain development. Defects in Rab 3 GAP p130 are the cause of Warburg micro syndrome 1 (WARBM1). WARBM1 is a severe autosomal recessive disorder characterized by developmental abnormalities of the eye and central nervous system and by microgenitalia. The Rab 3 GAP p130 protein may participate in neurodevelopmental processes such as proliferation, migration and differentiation before synapse formation, and non-synaptic vesicular release of neurotransmitters.
仅用于科研。不用于诊断过程。未经明确授权不得转售。
生物信息学
蛋白别名: KIAA0066; Rab 3 GAP p130; Rab3 GAP p130; RAB3 GTPase activating protein subunit 1 (catalytic); RAB3 GTPase-activating protein 130 kDa subunit; Rab3 GTPase-activating protein catalytic subunit; Rab3-GAP; Rab3-GAP p130
基因别名: 1700003B17Rik; 4732493F09Rik; AL117896; KIAA0066; MARTS2; P130; RAB3GAP; RAB3GAP1; RAB3GAP130; WARBM1
UniProt ID: (Human) Q15042, (Mouse) Q80UJ7
Entrez Gene ID: (Human) 22930, (Mouse) 226407